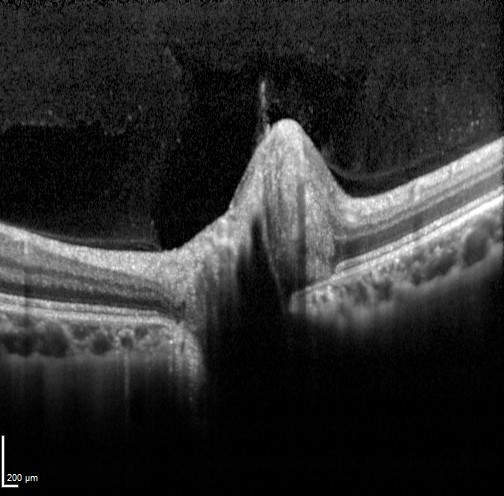

Overview
Small crowded optic discs are an anatomical variation caused by a normal amount of axons coursing through a small scleral foramen. This anatomical restriction of the area in which axons can enter the nerve results in a "heaped" optic nerve head appearance which can mimic true disc swelling.
Small crowded discs are commonly associated with hyperopia as a result of shorter axial length and patients are asymptomatic.
Clinical examination shows a smaller than normal disc with little to no visible cup. Fundus autofluorescence and B-scan ultrasound are unremarkable. OCT imaging shows an apparently elevated optic nerve with no apparent cup and a small Bruch's membrane opening. The retinal architecture adjacent to the optic disc is intact. The nerve may also show a "lumpy bumpy" appearance similar to that created by ONH drusen, however in a crowded disc this is actually due to posterior shadowing caused by the blood vessels trying to enter the small optic foramen. The hypo-reflective areas do not have the hyper-reflective borders seen in disc drusen (further information on disc drusen is available using the tab at the bottom of the page).
Case Examples
Differential Diagnosis
References
Arturo Carta, Stefania Favilla, Marco Prato, Stefania Bianchi-Marzoli, Alfredo A. Sadun, Paolo Mora; Accuracy of Funduscopy to Identify True Edema versus Pseudoedema of the Optic Disc. Invest. Ophthalmol. Vis. Sci. 2012;53(1):1-6.
Chiang, J., Wong, E., Whatham, A., Hennessy, M., Kalloniatis, M. and Zangerl, B. (2015), Differentiating optic nerve head swelling. Clin Exp Optom